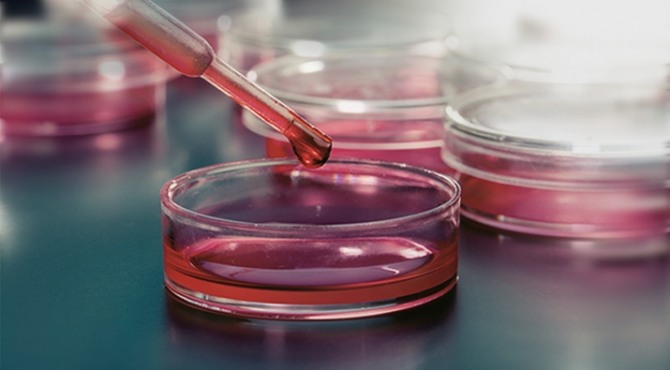

이미지 확대보기4일 한국거래소에 따르면 시너지이노베이션 주가는 이날 3870원에 마감해 전 거래일 2980원과 비교해 29.87%(890원) 상승하며 거래를 마쳤다.
지난 1일에도 상한가를 기록했던 시너지이노베이션은 이날 상승으로 4거래일 연속으로 상승세를 이어갔다.
시가총액도 껑충 뛰면서 3000억을 단숨에 돌파했는데 이날 하루동안 736억원 증가해 마감기준 시가총액은 3200억원을 기록했다.
이날 시너지이노베이션 전체 거래량은 788만주를 가량으로 전일 거래량의 6배 이상 급증했다.
한편 국내 최초로 120여종의 미생물배양용 배지를 대량생산, 판매하는 배지 전문업체 코메드생명과학㈜를 흡수합병하여 만들어진 ㈜시너지이노베이션 바이오사업본부는 전국 대부분의 병원, 검사센터 및 제약회사 등에 고품질의 생배지와 표준 균주를 공급하고 있다.
정준범 글로벌이코노믹 기자 jjbkey@g-enews.com
[알림] 본 기사는 투자판단의 참고용이며, 이를 근거로 한 투자손실에 대한 책임은 없습니다.